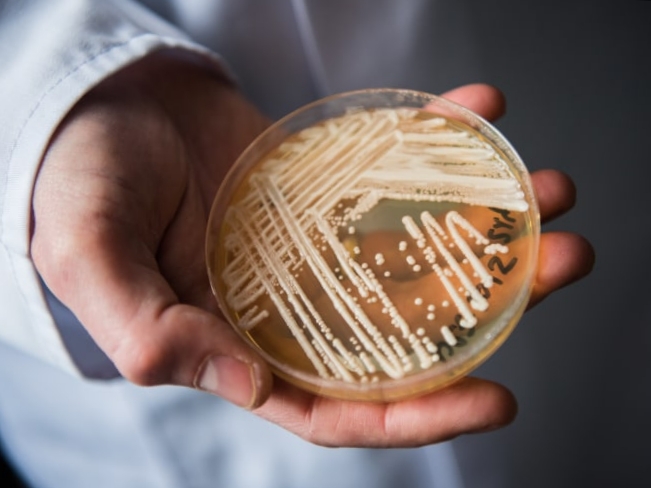

Sharing unique facts from around the world.
Popular
Artikel Terbaru
viral
- Kucing di jepang menjadikan pembatas parkir(Bumper) sebagai bantal untuk tidur
- Serangan Tikus terparah dalam beberapa dekade terakhir Menghantui Kota Prancis
- Kronologi Kecelakaan kereta api di India yang menewaskan lebih dari 280 orang, melukai 900 orang
- PLN berbagi 10 kiat terhindar dari listrik korsleting
- Berikut Penjelasan Ilmiah tentang Semburan Gas Bercampur Lumpur di Pesantren Kalimantan Barat
- WHO resmi mengakhiri deklarasi status darurat kesehatan global untuk COVID-19, berikut data yang dihimpun WHO
- 13 orang di India meninggal akibat gelombang panas. Bagaimana gelombang panas mampu membuat orang meninggal?
- Jamur mematikan menyebar dengan cepat lewat fasilitas perawatan di Amerika serikat
Nature
- Jerapah memiliki kesulitan minum dan makan rumput karena tinggi badannya,berikut cara mereka mengatasinya
- Anjing laut punya kemampuan ini agar bisa tidur di bawah air dan terhindar dari predator
- Rahasia kemampuan ular yang mampu memanjat pohot tanpa bantuan alat gerak dan cakar
- Garangan jawa terkenal dengan keberanian dan kekejamannya dalam bertarung.
- Kumbang trilobita yang membingungkan semua orang
- Tidak termasuk unggas air, apakah burung hantu memang bisa berenang?
- Seabin Pengumpul sampah yang terapung dapat membersihkan lautan dari sampah dan minyak
- Ular Ekor Laba-laba Adalah Makhluk Yang Mengerikan karena tipu dayanya dalam berburu
- Berikut beberapa kelebihan lidah anteater yang panjangnya mampu mencapai 60 cm
- Basket star, membahas asal usul nama pada bintang keranjang dan fakta unik lainnya
- Ilmuwan ciptakan lem untuk pembedahan medis yang terinspirasi dari lendir siput
- Bagaimana Garam dapat Membunuh Lintah?
- Inovasi Kulit kaktus menggantikan kulit binatang dan kulit sintetis sebagai bahan fashion
- African lungfish menjadi ikan paling kuat menghadapi kekeringan ekstrim saat musim kemarau di afrika, berikut cara mereka bertahan hidup.
- Kawanan antelop berjuang hidup dan mati agar selamat dari kawanan anjing hutan yang buas
- Siput laut monster asal California memiliki sistem reproduksi unik yang membuat mereka cenderung melakukan Party s*x saat kawin
Nebtov fact
Kami adalah sumber terpercaya dalam memberikan informasi dan fakta fakta menarik seputar alam teknologi sejarah dan lain lain
Hubungi Kami
+62 812-6316-5786
Nebtov@gmail.com